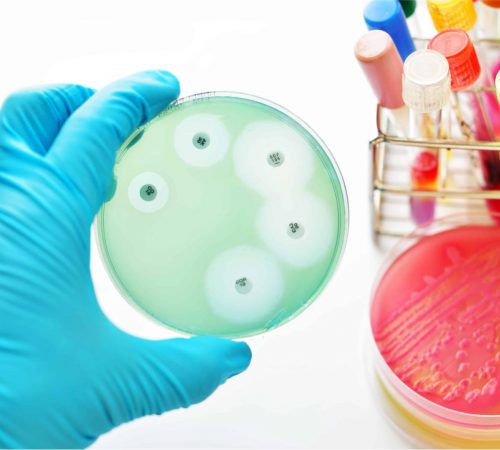
Extensively drug-resistant tuberculosis (XDR-TB)

Expert-Led, Cost-Effective Treatment for Complex Infections
Consult Dr. Ashwini Tayade Today for Expert Care for Complex Infections & Good Health
Avoid the risks of self-medication, prolonged illness, and recurrent infections. Receive specialized, ethical, reliable, quick, and cost-effective solutions for infections and good health from India’s leading Infectious Diseases Specialist, with close to Two Decades of global experience from the World’s best hospitals.
0
PATIENTSTREATED
24/7
EMERGENCYCARE
0
PATIENTSATISFACTION
1
MEDICALEXPERTS
Why Ishra Health?
In Ishra Health, we share the common aim of giving you effective healthcare. Our services have been designed to deliver the care that is best suited to your needs. The diagnosis and treatment of infectious diseases such as HIV, TB, Cancer and many more are cured at our place. Dr Ashwini Choudhary (Tayade) has been running this clinic for the last 7 years, with having rich experience in this field. She also visits Getwell Hospital, Nelson Hospital, Orange City Hospital and Central India Institute of Medical Sciences (CIIMS).
Our hospital provides highly advanced services which have revolutionised the way care was imparted to the patients. We have a keen watch on all significant drives towards doing valuable work. We are a trusted healthcare system that assures performance, care and compassion, safety, and the earliest possible recovery. Our hospital is equipped with 24*7 personalised care and emergency services With state-of-the-art infrastructure and a dedicated medical team, we strive to deliver excellence in healthcare at every stage of treatment..
treatments
Expert Infectious Diseases Care at Ishra Health for a Healthy ‘Swastha’ Life.
treatments
Expert Infectious Diseases Care at Ishra Health for a Healthy ‘Swastha’ Life

Services
Early Diagnosis | Advanced Treatment | Expert Ethical Cost-effective Care
Services
Early Diagnosis | Advanced Treatment | Expert Ethical Cost-effective Care
Fever Management
Expert diagnosis and treatment of prolonged or unexplained fevers.
Tuberculosis & Drug-Resistant TB
Advanced care for all forms of TB.
HIV & STDs
Confidential testing, counseling, and treatment.
Fungal & Parasitic Infections
Targeted therapies for complex infections.
Vaccinations
Preventive immunizations and travel vaccines.
UTIs
Effective treatment for recurring infections.
Bone Infections
Comprehensive osteomyelitis care.
Travel Medicine
Health advice for international travelers.
Services
Early Diagnosis | Advanced Treatment | Expert Ethical Cost-effective Care
Patient Care Journey
A step-by-step approach to accurate diagnosis, effective treatment, and ongoing support
Initial Consultation
We listen to our patients, discuss their health concerns and medical history.
Diagnostic Evaluation
Lab tests (reliable, quick, cost-effective) are available at NG Swastha to pinpoint the issue.
Personalized Treatment Plan
Individualized solutions for infections & health problems with a tailored approach.
Continuous Ongoing Support
Compassionate care and regular follow-ups to ensure optimal health.
Prevention of Recurrent Infections
Solutions & vaccinations for effective long-term prevention.
affiliations
Dr.Ashwini Tayade’s Esteeemed Affiliations Include
Dr.Ashwini Tayade’s Esteeemed Affiliations Include
Getwell Hospital
Senior Consultant in Infectious Diseases, delivering comprehensive patient-centered care.
Nelson Hospital
Affiliated specialist providing advanced infectious disease management and clinical expertise.
Orange City Hospital
Consultant in Infectious Diseases offering expert diagnosis and evidence-based treatments.
Central India Institute of Medical Sciences (CIIMS)
Associated consultant contributing to tertiary care, academics, and infectious disease excellence.
Testimonials
Patient Success Stories!
Testimonials
Patient Success Stories!
Pooja BachateTrustindex verifies that the original source of the review is Google. I visited Dr. Parimal tayde. He was very good and cooperative person. Explaining very good Mayur DhekleTrustindex verifies that the original source of the review is Google. मी माझ्या आई च्या उपचारा दरम्यानचा अनुभव.... शांत पण पुर्ण अयकुन घेणे त्या नंतर टप्प्या टप्प्यात समजुन सांगणे. कमीत कमी औषधी द्याचा प्रामाणिकपण दिसुन येते. पेशन्ट व त्याचे पालकांचे 25% तर त्यान्च्या बोलल्यानंतर तन तनाव कमी होते. फिज(त्याच्यां) कडे मेटर करित नाही.फारसे महत्त्व देत नाही. मॅडम च्या पत्ता मिळने माझ्या नशीब..... Nandini ChoudhariTrustindex verifies that the original source of the review is Google. Happy to be a part of ishrahelth . PRIYA DALNETrustindex verifies that the original source of the review is Google. Thank you Ashwini maam, I was very pleased with my experience at ishra health thank u for everything Poorvi AgrawalTrustindex verifies that the original source of the review is Google. Dr. ASHWINI TAYADE MAM “Has a way of explaining complex medical issues in a clear and concise manner. I feel so much more informed about my health. I was impressed by her attention to detail and thoroughness in diagnosing my condition. She goes above and beyond to ensure their patients feel comfortable and supported. They’re more than just a doctor- they’re a friend. I appreciate her willingness to listen and answer my questions. They truly put patients first. Her kindness and empathy make a huge difference in my treatment. I’m so lucky and grateful to have them on my care team.❤️”